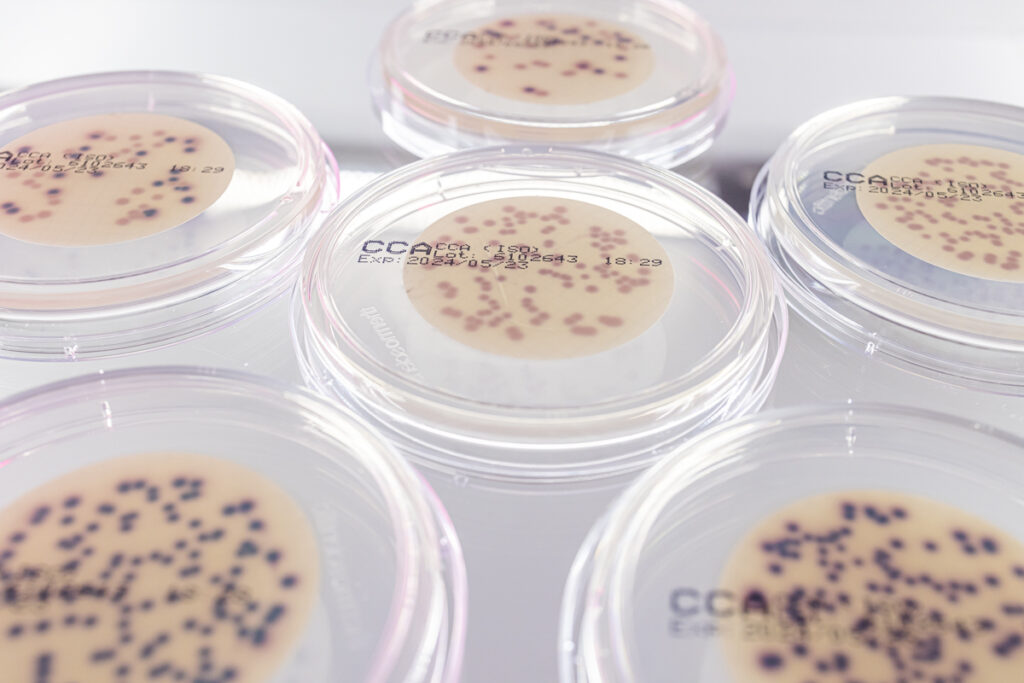
Mehrere Petrischalen mit transparenten Deckeln; auf Membranfiltern wachsen auf chromogenem Nährboden (CCA) violette und blau-dunkle Kolonien – Vorbereitung zur Koloniezählung in der Trinkwasseranalyse.

Zentrallabor Umweltmikrobiologie
Startseite » Leistungen » Umweltmikrobiologie & Wasserhygiene » Zentrallabor Umweltmikrobiologie
Abteilungsleiterin
Dr. Nicole Knabe
Auftragsabwicklung
Kerstin Blex
Cornelia Bremberg
Umweltproben
In dem Zentrallabor der Umweltmikrobiologie werden Umweltproben auf das Vorkommen von Mikroorganismen, in der Regel Bakterien, untersucht. Insbesondere Wasser aus Trinkwasserversorgungsanlagen, Schwimmbeckenwasser-Aufbereitungsanlagen, Verdunstungskühlanlagen und Kühltürme, Raumlufttechnischen-Anlagen, Kläranlagen, Dentaleinheiten, Ohrspülanlagen, Augen- und Notduschen uvm. wird mikrobiologisch analysiert. Auch in Proben von Oberflächen (Kontaktkulturen), Tupfer- oder Abstrichproben und Material aus Geräten und Apparaten werden Bakterien sowie Schimmelpilze und Hefen bestimmt.
Verfahren und Parameter
Die Bestimmung der Mikroorganismen erfolgt überwiegend über kulturelle
Verfahren (z.B. Oberflächenverfahren / Direktes Ausplattieren,
Plattengußverfahren, Membranfiltrations-verfahren, Most Probable
Number-/MPN-Verfahren, Mikrotiterverfahren). Dabei werden die Zielorganismen in
oder auf einem Nährmedium angezüchtet und anschließend quantitativ bestimmt.
Auch biochemische und mikroskopische Verfahren kommen zur Differenzierung und
Identifizierung der angezüchteten Mikroorganismen zum Einsatz.
Gemäß den Anforderungen der geltenden Gesetze, Verordnungen und anerkannten Regel der Technik sowie des Umweltbundesamtes und des LANUK NRW werden folgende Zielorganismen nach genormten Methoden untersucht:
- Koloniezahl bei 22°C und Koloniezahl bei 36°C
- Escherichia coli (E. coli)
- Coliforme Bakterien
- intestinale Enterokokken
- Pseudomonas aeruginosa
- Legionellen / Legionella spp.
- Salmonellen
- Clostridium perfringens
- Somatische Coliphagen
- Schimmelpilze und Hefen
Die dazugehörigen unterschiedlichen Methoden können in der Akkreditierungsurkunde nachgelesen werde
Sonderuntersuchungen
Je nach Problemstellung können auch andere Zielorganismen untersucht werden. Beispiel dafür sind Gesamtbakterienzahl, Schleimbakterien, Eisenbakterien sowie Sulfatreduzierende Bakterien.
In Abhängigkeit von mikrobiologischen Fragestellung und in Abstimmung mit dem Kunden können auch andere Verfahren, wie z.B. Gewinnung von Zellsuspensionen aus Rohstoffen, von Material- und Werkstoffoberflächen oder aus Geräten, zur Anwendung kommen.
Auch durch die Zusammenarbeit mit den anderen Abteilungen können weitere Verfahren, wie z.B. Rasterelektronenmikroskopie, Fluoreszenz- und Lichtmikroskopie, zur Bestimmung von Mikroorganismen angeboten werden.
Seit Neuestem bieten wir die Bestimmung des Krankheitserreger SARS-CoV-2 mittels molekularbiologischer Verfahren im belasteten Wasser. Über die qRT-PCR-Analytik (quantitative reverse Transkriptions-Polymerase-Kettenreaktionstest) werden verschiedener Genbereiche von SARS-CoV-2 nachgewiesen. Die Quantifizierung der amplifizierten Nukleinsäuren erfolgt durch den Vergleich mit einem internen spezifischen Standard. Die Ergebnisse liegen innerhalb von 24 bis 48 Stunden nach Eintreffen der Proben im Labor vor. In der Regel wird dieses Verfahren im Zulaufwasser (gekühlte 24 h-Mischprobe) von Kläranlagen angewendet.
Für mehr Informationen zu unserem Abwassermonitoring auf SARS-CoV-2 sprechen Sie uns an.
Unsere Sachgebiete in der Umweltmikrobiologie & Wasserhygiene
Entdecken Sie unsere spezialisierten Leistungen in der Analyse von Trinkwasserinstallationen und der Bewertung von Legionellen-Risiken. Erfahren Sie mehr über unsere Lösungen für sichere und hygienische Wasserqualität.